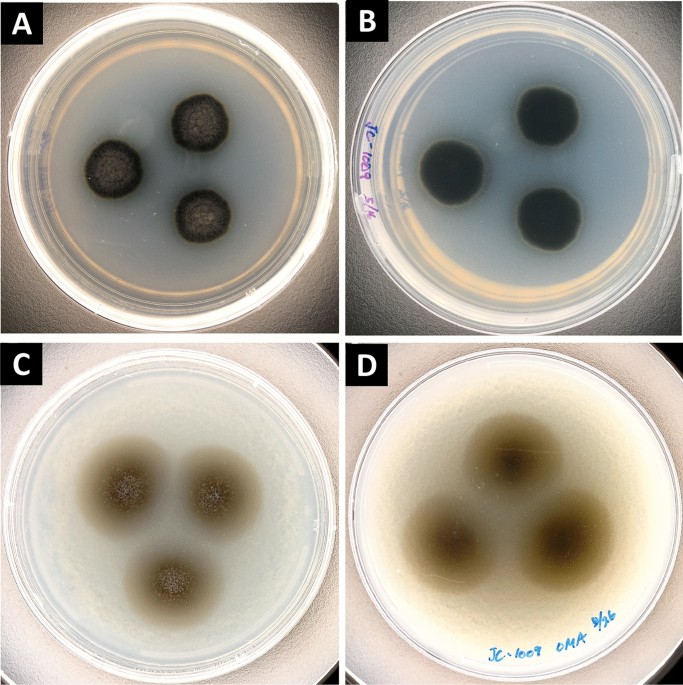
Nature

Rare strain of black fungus isolated from a Mars spacecraft assembly facility
Published in Astronomy, Social Sciences, and Microbiology

We are very pleased to present one of Scientific Reports’ latest articles, which demonstrates the difficulty and importance of protecting against micro-organisms during spacecraft . Maintaining a sterile environment at spacecraft assembly centers is critical for responsible interplanetary exploration: it ensures that we don’t contaminate life-finding missions with the local microbiota of Earth. However, in a recent paper, researchers investigating a spacecraft assembly facility located at the Jet Propulsion Laboratory in California have identified a polyextremophilic species of Knufia, a strain of black fungus potentially capable of enduring exposure to spaceflight and seeding extraterrestrial destinations.
The researchers isolated the fungi from the assembly facility and characterized their morphology via the latest microscopic techniques, finding that the morphology of the colony was melanized with yellow pigmentation near the periphery. The group also noted separate entities including dormant structures like chlamydospores and conidia, which are adaptive mechanisms to enable the fungi to survive in a wide range of conditions.
Sequencing and functional analyses revealed regions of core genomic conservation, which the authors considered likely to be strain-specific adaptations. They further identified genomic regions responsible for ubiquitin-dependent endocytosis for an evolved proteomic and metabolic trafficking capability within the cells. These specialisations result in efficient nutrient utilization processes, further supporting the adaptability of the strain. This characteristic adaptability underlies the survival of this strain in a variety of unusual or extreme habitats, including cold and hot deserts, high-salt content environments, and one instance recounted by the authors of the fungi being discovered in the gasoline tank of a car!
The wide range of habitability of Knufia extends the risk if it’s inadvertently introduced in spacecraft assembly facilities. The presence of these highly resilient species of black fungi in the sensitive environments of spacecraft assembly facilities (SAFs) could pose a risk of contamination to other planets. This could be a serious concern for space exploration missions which aim to detect life on other planets. This article therefore raises the need for a decontamination drive in SAFs to avoid any contamination during space exploration mission.
Follow the Topic
-
Scientific Reports
An open access journal publishing original research from across all areas of the natural sciences, psychology, medicine and engineering.
Related Collections
With Collections, you can get published faster and increase your visibility.
Phytochemicals and health
Publishing Model: Open Access
Deadline: Jul 28, 2026
Health Policy and Systems Research
Publishing Model: Hybrid
Deadline: Jul 14, 2026

Please sign in or register for FREE
If you are a registered user on Research Communities by Springer Nature, please sign in